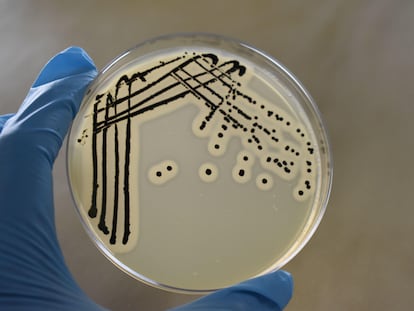

Hallada una bacteria helada hace 5.000 años capaz de plantar cara a superpatógenos
El microorganismo recién descubierto parece mostrar resistencia a una decena de modernos antibióticos, pero también inhibe el crecimiento de otras bacterias

Cuando tu cuerpo se convierte en una cervecería: un estudio desvela los misterios del síndrome de autofermentación
Una investigación identifica las bacterias responsables de un raro trastorno que provoca intoxicación sin beber alcohol, y plantea una solución: el trasplante de heces

Las doctrinas de Trump
Las lectoras y los lectores escriben sobre la política exterior de EE UU, la educación emocional, el acuerdo UE-Mercosur y los propósitos de año nuevo
Un virus también puede salvar vidas: así funciona la fagoterapia
Los fagos le salvan la vida a Irene, que recibió y rechazó cuatro pulmones trasplantados
Científicos y médicos se sirven de estos virus que atacan a las bacterias para eliminar una infección resistente a los antibióticos que afectó a una paciente valenciana durante 30 años

La IA descubre antibióticos en arqueas, los microorganismos que explican el origen de la vida compleja
Uno de los compuestos arroja resultados equiparables a fármacos utilizados como último recurso en infecciones resistentes a medicamentos existentes

Por qué los mosquitos te pican más a ti (y qué hacer para evitarlo este verano)
No afectan a todos por igual: prevenirlas y tratarlas ayuda a evitar reacciones intensas o enfermedades que van más allá de las típicas molestias

Un gen que convierte las bacterias en superbacterias se extiende por hospitales y granjas
Un equipo internacional de científicos ha descubierto en cuatro continentes un fragmento genético que hace que los microbios sean resistentes a toda una familia de antibióticos

Las resistencias bacterianas llevan a la EMA a restringir el uso de la azitromicina, el popular antibiótico de las tres pastillas
El fármaco, cuyas ventas han crecido en España un 13,8% en solo dos años, dejará de prescribirse para combatir, entre otras afecciones, el acné y la helicobacter
El fiscal pide investigar la “grave” contaminación de las macrogranjas en As Conchas: la Xunta era “consciente” y no lo “remedió”
Las Administraciones demandadas por los vecinos “no solo no ejercieron ningún control sobre las explotaciones ya autorizadas sino que continuaron autorizando nuevas”, reprocha el ministerio público

El primer antibiótico descubierto en 30 años llega justo a tiempo de evitar que la supergonorrea sea imposible de tratar
La gepotidacina elimina la bacteria de transmisión sexual en el 93% de los casos, en plena emergencia mundial por la falta de nuevos antimicrobianos

‘Podcast’ | ¿Nos va a salir más caro ir al veterinario?
Una reciente normativa obliga a los veterinarios a informar de los antibióticos que prescriben. Los dueños de las mascotas deben de comprarlos en la farmacia
Demanda pionera contra la contaminación ganadera: afectados de As Conchas alegan “vulneración de derechos fundamentales”
Vecinos y ecologistas denuncian a la Xunta de Galicia y otras entidades ante el Tribunal Superior por los vertidos de macrogranjas y argumentan que los antibióticos usados en los animales generan resistencias en los humanos

Una rana apestosa facilita el desarrollo de antibióticos sintéticos contra patógenos resistentes
Una investigación a partir de las secreciones de un anfibio desvela la fórmula para el diseño de fármacos que no dañan a las células sanas y respetan la microbiota

Bruselas acelera para garantizar el abastecimiento de medicamentos críticos en tiempos convulsos
La Comisión Europea ultima una ley que reduzca la dependencia de terceros países en la producción de ingredientes y medicinas básicas como el paracetamol o los antibióticos

Hastío entre los veterinarios por la nueva normativa europea: “No somos sanitarios de segunda”
El Colegio de Veterinarios de Barcelona calcula que la prescripción de antibióticos se ha reducido un 70% para disminuir la resistencia a estos fármacos pero denuncia el menoscabo al criterio de los profesionales

Las superbacterias matan ocho veces más de lo estimado hasta ahora por Sanidad, según un estudio
Una novedosa investigación llevada a cabo en 130 hospitales de España por especialistas en microbiología y enfermedades infecciosas revela un mayor impacto de la resistencia a los antibióticos en los pacientes

Los veterinarios se manifiestan en Barcelona contra la nueva ley que dificulta la dispensación de tratamientos
El colectivo también reivindica una rebaja del IVA de sus servicios, que es del 21 %, a diferencia del resto de servicios sanitarios a los cuales no se les aplica este impuesto

Un ejército de virus contra las superbacterias: la ciencia recupera los fagos para combatir las resistencias a los antibióticos
Miles de pacientes tratados avalan el potencial de la fagoterapia, pero el conocimiento limitado de esta técnica y su complejidad regulatoria lastran su expansión

Un brote letal de la bacteria ‘Klebsiella oxytoca’, la última batalla en los hospitales mexicanos
La Secretaría de Salud investiga la muerte de 13 niños y la hospitalización de otros siete a causa de un supuesto contagio con este microorganismo. Una contaminación de insumos médicos en el Estado de México es la pista principal

La investigación latinoamericana se abre camino contra las bacterias resistentes
Científicos de Colombia, Chile y Uruguay desarrollan estrategias innovadoras para suplir la falta de antibióticos efectivos. La OMS solo ha identificado tres proyectos en esta vía en América Latina

“Tómate esto que a mí me va genial para el dolor”: por qué los jóvenes se automedican cada vez más
Se consumen más medicamentos sin prescripción médica cuando la frecuencia es semanal o mensual por la percepción errónea, según advierten los expertos, de que el riesgo es menor

La falta de suministro de fármacos contra el TDAH en España evidencia los problemas de Europa para combatir la escasez de medicamentos
La comercialización del Concerta no quedará normalizada hasta el año que viene. La UE prepara una nueva normativa para reducir su dependencia de las importaciones de Asia

Ben Feringa, Nobel de Química: “Una sola célula es más compleja que toda una ciudad”
El científico holandés diseña las máquinas más pequeñas del mundo, incluidos fármacos que se activan con luz para mejorar los tratamientos contra el cáncer o las infecciones

Orgullo de ser autónomo
Los lectores escriben sobre la explotación laboral, la legitimidad del Gobierno, las imposiciones sociales y el uso responsable de los antibióticos

Uno de los tratamientos contra la helicobacter, una frecuente infección gástrica, se convierte en el fármaco con mayor desabastecimiento
Los médicos optan por la alternativa, una combinación de tres antibióticos, que tiene similar eficacia para un problema muy extendido

Nace una nueva medicina que aplica la teoría de la evolución a combatir el cáncer o las pandemias
El primer programa conjunto de investigación en genómica médica evolutiva del mundo se presenta en Barcelona, bajo la dirección del biólogo Manuel Irimia

Descubierto un nuevo gen de resistencia a los antibióticos oculto en el microbioma
Una investigación apunta que el ecosistema de microbios que hay en el intestino puede ser un reservorio de genes resistentes que saltan de una bacteria a otra
Descubierta la doble defensa de una superbacteria para sortear a los antibióticos
El ‘Staphylococcus aureus’ resistente a la meticilina, que causa 120.000 muertes al año, adopta un modo alternativo de división celular para asegurar su supervivencia
Una investigación descubre antibióticos ocultos en proteínas de sistemas ajenos al inmunitario
El trabajo, dirigido por el español César de la Fuente, transforma la comprensión de la respuesta del cuerpo a las infecciones y abre la vía a tratamientos contra microbios resistentes a los medicamentos
Alertas rojas para la salud
El incremento de las brechas socioeconómicas unido al deterioro de los factores medioambientales que favorece la proliferación de enfermedades como el virus del Nilo, el dengue o la malaria, así como a la resistencia a los antibióticos, componen un cóctel extremadamente peligroso para el bienestar de la humanidad

Una enorme (y desconocida) diversidad de virus prolifera en tu cepillo de dientes y en el cabezal de la ducha
Un nuevo estudio encuentra miles de virus bacteriófagos, con un potencial uso biomédico para la lucha contra la resistencia a antibióticos, en los baños de EE UU
Dirigentes de todo el mundo se comprometen a actuar para garantizar el futuro de la medicina moderna
La resistencia a los antibióticos, una amenaza a los avances clínicos de la humanidad, está asociada a más de un millón de muertes al año

La resistencia a los antibióticos, el problema que amenaza con matar a 208 millones de personas en 25 años
Un estudio publicado en ‘The Lancet’ advierte de que los fallecimientos por enfermedades que no responden a los antimicrobianos crecerán de forma dramática entre los mayores de 70 años

Elisabeth Stampa, patronal de genéricos: “Muchos fármacos que se producían en Europa ahora se fabrican en Asia. Esto nos hace vulnerables”
La española, presidenta de Medicines for Europe, considera que el suministro de medicamentos esenciales está en riesgo si los gobiernos no permiten revisar el precio de los más baratos con la inflación

Las enfermeras podrán recetar antibióticos para la cistitis: “Ahora tengo que ir a urgencias y esperar horas con un dolor fortísimo”
El Ministerio de Sanidad ha aprobado un reglamento que tendrán que aplicar las comunidades y que ha sido contestado por los médicos, que consideran que la prescripción es de su exclusiva competencia
Augmentine: los riesgos de “usar para curarlo todo” un antibiótico que pocas veces hace falta
Datos del sector farmacéutico revelan un uso excesivo en España de la combinación de amoxicilina con ácido clavulánico, un fármaco que destruye la flora intestinal durante nueve meses y cuyo uso innecesario facilita que las bacterias desarrollen resistencias

El ataque de los “clones epidémicos”: cómo una bacteria inofensiva llegó a causar medio millón de muertos al año
Un grupo de investigadores británicos describen la evolución de las ‘Pseudomonas aeruginosa’ durante los últimos 200 años hasta aprovechar un defecto inmunológico para enfermar a pacientes con fibrosis quística

¿Por qué en verano tengo más cistitis?
Llevar ropa húmeda, la deshidratación y las relaciones sexuales son algunos de los factores relacionados con la infección de orina